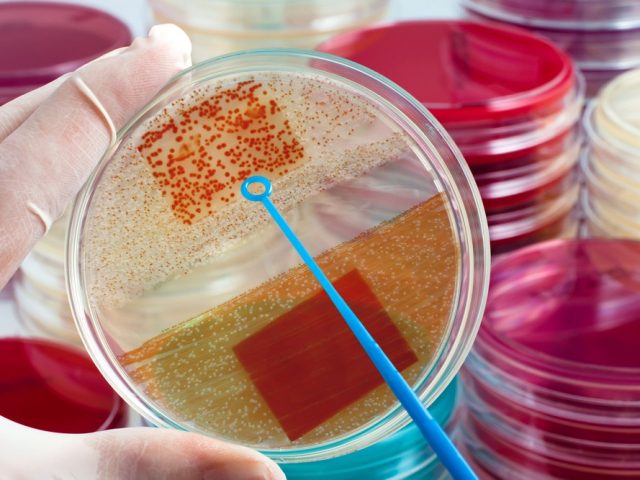

چه چیزی باعث ناباروری زنان میشود؟ تعریف، علائم و درمان

ناباروری زن، ناتوانی در باردار شدن به دلیل مشکلات مربوط به تخمک است که مانع لقاح و در نتیجه بارداری میشود. تغییر ظرفیت تولیدمثلی میتواند به دلایل مختلفی ظاهر شود که بسته به علت آن، علائم کم و بیش قابل توجه خواهد بود.
به همین دلیل، ممکن است شرایطی پیش بیاید که زن تا زمانی که آزمایشهای باروری مربوطه را انجام ندهد، از ناباروری خود آگاه نباشد.
دو نوع اصلی ناباروری وجود دارد:
عقیمی اولیه
در زنانی که قبلا باردار نشدهاند، ظاهر میشود.
عقیمی ثانویه
زمانی که یک زوج قادر به بارداری نیستند، حتی اگر قبلاً یک یا چند فرزند مشترک داشته باشند. به طور خلاصه، عقیمی پس از بارور شدن قبلی ظاهر میشود.
اگرچه این دو نوع ناباروری متفاوت هستند، اما نقطه مشترک بین آنها دشواری در رسیدن به بارداری مطلوب است.
ناباروری و نازایی در زنان
اگرچه واژههای عقیمی و ناباروری معمولاً بهعنوان مترادف هم از سوی جامعه و هم از سوی متخصصان این حوزه استفاده میشوند، اما باید توجه داشت که معنای آنها دقیقاً یکسان نیست:
عقیمی زنانه
همجوشی بین تخمک و اسپرم، یعنی لقاح، به دلیل مشکلات مربوط به سلول تخمک نمیتواند انجام شود. همچنین، هنگامی که لقاح اتفاق میافتد، ما در مورد عقیمی صحبت میکنیم، اما همچنان، جنین قادر به اتصال به پوشش آندومتر نیست. به طور خلاصه، به هر موقعیتی اشاره دارد که در آن حاملگی نمیتواند اتفاق بیفتد.
ناباروری زنان
اگرچه لقاح اتفاق میافتد و جنین در نتیجه اتصال تخمک به اسپرم به دست میآید، نمیتواند به رشد کامل خود ادامه دهد، بنابراین حاملگی کامل هرگز رخ نمیدهد. باعث سقط جنین زن میشود.
به هر حال، هر دو نوع مانع از توانایی زن برای بچه دار شدن میشوند، و بنابراین، هنگام صحبت در مورد علل، علائم و درمانهای بالقوه برای رسیدن به بارداری موفق، به جای یکدیگر استفاده میشوند.

علل ناباروری در زنان
مشکلات ناباروری در زنان میتواند به دلیل یکی یا ترکیبی از تغییرات زیر ظاهر شود:
مشکلات تولید تخمک
یکی از دلایل اصلی ناباروری زنان با چرخه تخمکگذاری مرتبط است. این ناباروری به عنوان عامل غدد درون ریز شناخته میشود زیرا چرخه قاعدگی توسط مجموعهای از هورمونها مانند GnRH (هورمون آزاد کننده گنادوتروپین)، FSH (هورمون محرک فولیکول)، LH (هورمون لوتئین کننده)، پروژسترون و استرادیول تنظیم میشود.
تغییرات در سطح هورمون میتواند منجر به موارد زیر شود:
- عدم تخمکگذاری
- تخمکگذاری زودتر یا دیرتر از حد انتظار انجام میشود
- شکست در تولید تخمک
در چرخههای قاعدگی طبیعی، بدون تغییرات غدد درون ریز، تخمکگذاری در نیمه چرخه قاعدگی (تقریباً در روز ۱۴) انجام میشود، با در نظر گرفتن روز اول، روز شروع دوره قاعدگی.
به همین دلیل، بارورترین روزها نزدیکترین روزها به تخمکگذاری است، یعنی لحظهای که تخمک توسط تخمدان آزاد میشود تا اسپرم امیدوارانه به آن برسد و آن را در داخل لوله فالوپ بارور کند.
اگر زنی هر یک از مشکلات ذکر شده در بالا مربوط به تخمکگذاری را داشته باشد، حتی اگر در سیکل باروری خود سعی در باردار شدن داشته باشد، احتمال بارداری وجود ندارد.

اختلال تخمکگذاری
تغییرات در چرخه تخمکگذاری منجر به بینظمی قاعدگی یا حتی آمنوره (عدم قاعدگی) میشود. با این حال، موارد خاصی وجود دارد که در آن دورههای قاعدگی ظاهراً طبیعی است، حتی اگر یک سری مشکلات مربوط به هورمونها وجود داشته باشد که مانع از شانس بارداری زن میشود:
شکل پنهان نارسایی زودرس تخمدان (POF)
این نوعی نارسایی زودرس تخمدان (POF) است که از تخمکگذاری جلوگیری میکند.
نقص فاز لوتئال (LPD)
پس از تخمک گذاری، در مرحله لوتئال چرخه قاعدگی، ترشح پروژسترون انجام میشود و وظیفه اصلی آن ترویج رشد آندومتر برای ایجاد یک محیط مناسب برای لانه گزینی جنین و بارداری است. گاهی اوقات، پوشش آندومتر به دلیل تولید ضعیف پروژسترون به درستی رشد نمیکند، که باعث میشود بارداری امکانپذیر نباشد.
سندرم لوتئینیزه فولیکول پاره نشده (LUF)
فولیکول که محل قرارگیری تخمک قبل از تخمکگذاری است، تا زمانی که فاز لوتئال شروع شود به رشد خود ادامه میدهد، اگر هیچ تخمکی در داخل آن آزاد نشده باشد. لقاح رخ نخواهد داد.
برخی از عللعدم تعادل هورمونی که بر تنظیم چرخههای تخمدانی سیستم غدد درون ریز تأثیر میگذارد عبارتند از:
- استرس
- چاقی
- بیاشتهایی
- مشکلات تیروئید
- برخی داروها
- شیمی درمانی و رادیوتراپی
- عوامل محیطی
- و…
از شما خواسته میشود که برای بررسی رشد چرخه تخمدان خود از طریق اسکن اولتراسوند و آزمایش خون، تحت یک آزمایش قرار بگیرید. با انجام این کار، متخصص زنان شما قادر خواهد بود سطوح هورمونی شما را تجزیه و تحلیل کند و تعیین کند که آیا یک اختلال غدد درون ریز وجود دارد که ممکن است از بارداری جلوگیری کند.

مشکلات لوله فالوپ
هنگامی که به تغییرات یا مشکلات در لولههای فالوپ اشاره میکنیم، از اصطلاح ناباروری فاکتور لولهای استفاده میکنیم، بخشی از سیستم تولید مثل زنان که در آن لقاح انجام میشود.
طی تخمک گذاری، یک تخمک از تخمدان آزاد میشود و به لولههای فالوپ میرود، به طوری که یک اسپرم به آن رسیده و آن را بارور میکند. پس از لقاح، جنین حاصل از طریق لولهها به سمت رحم حرکت میکند، جایی که لانه گزینی میکند و باعث بارداری جدید میشود.
برای انجام این مراحل، باز بودن لوله در هر دو لوله فالوپ یا حداقل در یکی از آنها ضروری است. اگر هر دو لوله مسدود شده باشد، در نظر میگیریم که زن از ناباروری فاکتور لولهای رنج میبرد.
ناهنجاریهای مربوط به بسته بودن لولهها میتواند ناشی از عفونتها، اندومتریوز، سالپنژیت، ناهنجاریهای لوله، هیدروسالپینکس، جراحی، بیماری التهابی لگن (PID) و غیره باشد.
هیستروسالپنگوگرافی (HSG) یک آزمایش تشخیصی است که به ما امکان میدهد عملکرد لولههای رحمی را ارزیابی کنیم.

فاکتور دهانه رحم
دهانه رحم اولین جایی است که اسپرم باید در مسیر رسیدن به تخمک از آن عبور کند. ممکن است انسدادهایی به شکل پولیپ یا فیبروم وجود داشته باشد که مانع لقاح شود.
از سوی دیگر، مخاط دهانه رحم نیز به اسپرم کمک میکند تا در داخل رحم حرکت کند و وسیلهای را برای آنها فراهم میکند تا از طریق آن حرکت کنند.
برخی از دلایلی که مانع از رسیدن اسپرم به لولههای فالوپ برای بارور شدن تخمک و باعث ناباروری در زنان میشود، التهاب، عفونت یا تغییرات pH است.
ناباروری با منشا رحمی
ناباروری زنان به دلیل ناهنجاریهای رحمی دو دلیل اصلی دارد: از یک سو ناهنجاریهای رحمی و از سوی دیگر شرایط مربوط به آندومتر.
ناهنجاریهای رحمی میتوانند مادرزادی باشند، یعنی از بدو تولد، یا در ثانویه باشد و در نتیجه پولیپ، میوم یا کیست ظاهر شوند.
همچنین باید در نظر داشت که آندومتریوز یک علت ناباروری با منشاء رحمی نیز میباشد.
سایر علل ناباروری
عوامل دیگری نیز وجود دارند که بر باروری تأثیر میگذارند، اما میتوانند در هر دو جنس رخ دهند، مانند موارد زیر:
ناباروری بدون دلیل
علیرغم انجام آزمایشات باروری متعدد در زنان و مردان، اختلال خاصی که باعث ناباروری شود، شناسایی نشده است.
ناباروری ایمنی
شایعترین علت عقیمی ایمنی وجود آنتی بادیهای ضد اسپرم است که توسط زن یا مرد ایجاد میشود و همچنین سندرم آنتی فسفولیپید (APS) است که در ارگانیسم زن حالتی بیش از حد انعقاد ایجاد میکند که از کارکرد جفت جلوگیری میکند. به درستی و منجر به سقط جنین میشود.
پریشانی روانی
عواطف و احساسات نقش عمدهای در ظرفیت تولید مثل زنان دارند. برای ما غیرمعمول نیست که شاهد مواردی از زوجهایی باشیم که زمانی نابارور بودهاند، اما در تلاش دوم به بارداری طبیعی رسیدهاند. برخی متخصصین این وضعیت را با آرامش و از بین بردن استرس ناشی از ناباروری مرتبط میدانند.
شرایط واژن
واژینیسموس به دلیل انقباض عضلات دور واژینال از دخول و در نتیجه انزال جلوگیری میکند.
علل ژنتیکی
برخی تغییرات ژنتیکی و کروموزومی میتواند باردار شدن را برای یک زوج دشوار یا غیرممکن کند. علاوه بر این، آنها میتوانند بر رشد طبیعی بارداری تأثیر بگذارند و در نتیجه منجر به از دست دادن بارداری شوند.

درمان ناباروری
ناباروری زنان را میتوان با داروهای باروری برای تحریک تخمک گذاری، جراحی یا کمک باروری برطرف کرد. با این حال، روش انتخابی به علت ناباروری و شدت آن بستگی دارد.
درمانهای ناباروری
لقاح داخل رحمی (IUI)، رایجترین نوع لقاح مصنوعی که امروزه مورد استفاده قرار میگیرد، و لقاح آزمایشگاهی (IVF) رایجترین روش کمک باروری است که برای حل مشکلات مربوط به ناباروری یا عقیمی زنان استفاده میشود.
در حالی که IUI روشی است که کمترین سطح پیچیدگی را در بر میگیرد، زیرا اسپرمها در داخل رحم قرار میگیرند، شانس موفقیت آن کمتر است و زن باید یک سری از الزامات قبلی را برآورده کند.
از سوی دیگر، IVF شامل بازیابی تخمکهای بالغ از بیمار یا اهداکننده تخمک، لقاح آنها در آزمایشگاه با اسپرم شوهر یا اسپرم اهدایی و انتقال جنینهای حاصل به رحم زن است.
ناباروری زنان بر اساس سن
برخلاف آنچه در مردان اتفاق میافتد، زنان تخمک جدیدی تولید نمیکنند: آنها با مقدار محدودی تخمک متولد میشوند. از زمان بلوغ تا شروع یائسگی، تخمکگذاری میکنند.
سن باروری یک زن از ۱۶ سالگی شروع میشود و تا حدود ۳5 تا 40 سالگی ادامه دارد. از سن ۴۰ سالگی، باروری به تدریج شروع به کاهش میکند تا پایان کامل ذخیره تخمدان و رسیدن به دورهای به نام یائسگی.
سبک زندگی امروزی باعث شده است که بسیاری از زنان مادر شدن را به تاخیر بیندازند و در سنین بالا به فکر مادر شدن بیفتند. به همین دلیل است که امروزه بالا رفتن سن مادر علت اصلی ناباروری در زنان است.
درمانها
در شرایط ناباروری زنان، درمان لازم برای رسیدن به بارداری بستگی به علت ایجاد کننده آن دارد. بنابراین، متخصصان توصیه میکنند که هر مورد به صورت جداگانه بررسی شود و یک پروتکل درمانی شخصی ایجاد شود.
پس از تجزیه و تحلیل هر مورد و انجام تمام آزمایشات تشخیصی لازم، درمانهای باروری که یک زن یا زوج میتوانند برای داشتن فرزندانجام دهند به شرح زیر است:
مقاربت برنامه ریزی شده
برای موارد ناباروری خفیف، مانند عدم تخمکگذاری در زنان جوان. برای این منظور داروهای محرک تخمکگذاری تجویز میشود و برای مقاربت برنامهریزی میشود.
لقاح مصنوعی (AI)
اولین روش کمک باروری است که در زمانی که زن جوان است و اسپرم شریک زندگی از کیفیت خوبی برخوردار است استفاده میشود.
لقاح آزمایشگاهی (IVF)
برای ناباروری شدیدتر زنانه یا مردانه، یا زمانی که لقاح مصنوعی پس از چندین بار تلاش عمل نکرده است.
IVF با تشخیص ژنتیکی قبل از لانه گزینی (PGD)
در موارد ناباروری به دلایل ژنتیکی یا زمانی که خطر انتقال بیماری ارثی وجود دارد.

تخمک اهدایی
زمانی که زن در ذخیره تخمدان خود تخمک با کیفیتی نداشته باشد، باید به تخمک اهداکننده متوسل شود.
هر یک از این درمانها باید برای هر زن با توجه به ویژگیهای خاص و علل ناباروری او تطبیق داده شود.
سوالات متداول درباره ناباروری
آیا به دلیل سنم ممکن است مشکلات باروری داشته باشم؟
بله، متأسفانه گذشت زمان تأثیر بسیار منفی دارد. سن باروری بین بلوغ و یائسگی است. در این مدت بهترین شرایط معمولا تا ۳۵ سالگی است. با افزایش سن یک زن، ذخیره تخمدان و کیفیت تخمک او کاهش مییابد.
به طور خلاصه، هر چه سن یک زن بیشتر میشود، باروری او نه تنها به کاهش احتمال بارداری منجر میشود، بلکه به افزایش تعداد سقط جنین به دلیل ناهنجاریها و عوارض کروموزومی در دوران بارداری نیز منجر میشود.
چه زمانی میگویند زن نابارور است؟
زمانی که زنی در طی ۱ سال پس از داشتن رابطه جنسی محافظت نشده به طور منظم نباشد، نابارور است.
انواع مختلفی از علل با شدت بیشتر یا کمتر وجود دارد. به همین دلیل است که در بسیاری از موارد ممکن است تا قبل از انجام آزمایشات لازم عقیمی، زن از مشکل خود آگاه نباشد، زیرا در بسیاری از موارد هیچ علامتی از خود نشان نمیدهد.
تا چه سنی میتوانم مادر شوم؟
این به هر زن و ذخیره تخمدان او بستگی دارد. یک زن تا زمانی که به مرحله یائسگی نرسد، میتواند به طور طبیعی مادر شود. با این حال، با نزدیک شدن به این مرحله، ظرفیت تولید مثل کاهش مییابد.
در هر صورت و به طور کلی میتوان گفت که از سن ۳۵ سالگی به بعد، باروری زنان به تدریج کاهش مییابد و از ۴۰ سالگی به بعد این امر به میزان قابل توجهی کاهش دارد.